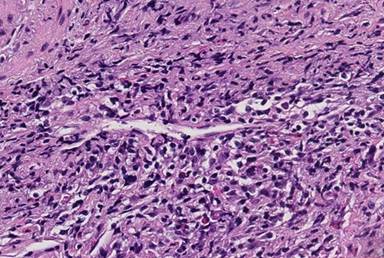

REVIEW
JOP. J Pancreas (Online) 2015 May 20; 16(3):239-243.
Autoimmune Pancreatitis: A Succinct Overview
Juan Putra, Xiaoying Liu
Department of Pathology, Dartmouth-Hitchcock Medical Center, One Medical Center Drive. Lebanon, NH, USA
ABSTRACT
Autoimmune pancreatitis is a rare type of chronic pancreatitis with characteristic clinical, radiologic, and histopathologic findings. Diagnosis of autoimmune pancreatitis is often challenging due to its low incidence and nonspecific clinical and radiologic findings. Patients with autoimmune pancreatitis and pancreatic cancer share similar clinical presentations, including obstructive jaundice, abdominal pain and weight loss. Due to these overlapping features, autoimmune pancreatitis patients are often misdiagnosed with pancreatic cancer and undergo unnecessary surgery. International consensus diagnostic criteria for autoimmune pancreatitis lists 5 cardinal features to establish the diagnosis of autoimmune pancreatitis. These features include imaging, serology, other organ involvement, histopathology of the pancreas, and response to steroid therapy. Endoscopic ultrasound-guided fine needle aspiration is a routine diagnostic tool for pancreatic lesions. It is usually utilized to exclude a malignant process in autoimmune pancreatitis patients, since its role to establish a definitive diagnosis of autoimmune pancreatitis is often limited. Endoscopic ultrasound-guided-tru-cut biopsy and endoscopic ultrasound-guided fine needle using a large gauge needle (19 to 22 gauges) have been the preferred methods to obtain tissue samples for histologic evaluation. Lymphoplasmacytic infiltrates, fibrotic stroma, mildly atypical epithelial cells, periphlebitis, and obliterative periphlebitis are the common histologic findings of type 1 autoimmune pancreatitis. Meanwhile, granulocytic pancreatic ductal epithelial damage and ductal obliteration are the histologic characteristics of type 2 autoimmune pancreatitis. Immunohistochemical and molecular studies may be helpful to support the diagnosis of AIP in biopsy materials.
INTRODUCTION
Autoimmune pancreatitis (AIP), a term introduced by Yoshida et al. in 1995, represents a type of chronic pancreatitis which is associated with frequent elevations of serum IgG4 levels, characteristic histologic findings, and a predictable response to corticosteroid [1, 2]. The condition was initially described in 1961 by Sarles et al. as primary inflammatory sclerosis of the pancreas [3]. AIP patients often present with painless jaundice in the setting of pancreatic mass, similar to patients with pancreatic or biliary cancer. The similar presentations between these patients put AIP patients at risk for unnecessary surgical resection [4]. Hardacre et al. reported that 2.5% of pancreaticoduodenectomy procedures were performed in AIP patients, because they were misdiagnosed as malignant lesions [5]. Endoscopic ultrasound-guided fine needle aspiration (EUS-FNA) has become widely utilized to diagnose pancreatic lesions. In AIP patients, EUS-FNA plays an important role to confirm the diagnosis and to exclude malignancy. Here we review the manifestations, diagnosis, and management of AIP, with an emphasis on the diagnostic utility of EUS-FNA.
EPIDEMIOLOGY AND CLASSIFICATION
AIP is a rare entity with a prevalence of 5-11% of all patients with chronic pancreatitis [6, 7]. It occurs predominantly in men who are older than 50 years of age [6]. The disease is classified into 2 subgroups, type 1 and type 2 AIP, based on its histological characteristics. The histologic pattern of type 1 AIP is described as lymphoplasmacytic sclerosing pancreatitis, characterized by periductal lymphoplasmacytic infiltrates, storiform fibrosis, and obliterative venulitis [8]. This type of AIP is associated with elevated immunoglobulin G4 (IgG4) levels in the serum and it is described as the pancreatic manifestation of IgG4-associated systemic disease. Meanwhile, idiopathic duct centric pancreatitis, characterized by granulocytic pancreatic ductal epithelial damage and ductal obliteration, is the histologic feature of type 2 AIP. It is usually not associated with any systemic disease or elevated levels of serum IgG4 [8, 9]. Type 1 AIP is the most common type of AIP in the United States and Japan, while type 2 AIP is more frequently seen in Europe [10]. Furthermore, patients with type 1 AIP are usually older than those with type 2 AIP.
Clinical and Radiological Findings
The clinical manifestations of AIP are similar to those of pancreatic cancer. The most common presenting symptom is painless jaundice, reported in 70% patients, secondary to the entrapment of intrapancreatic bile duct by the inflamed pancreatic parenchyma [11]. Other frequent symptoms include weight loss and mild abdominal pain, while episodes of acute pancreatitis are unusual. Type 1 AIP is associated with other organ involvement, such as sclerosing cholangitis and sclerosing sialadenitis. Meanwhile, type 2 AIP is frequently associated with inflammatory bowel disease [12]. Immunologic evaluation of type 1 AIP patients often reveals elevated levels of IgG and/ or gamma globulin. While the levels of these markers are usually normal in patients with type 2 AIP. Autoantibodies against lactoferrin and carbonic anhydrase II, antigens which are present in acinar and ductal cells, have been identified as potential serologic markers of AIP patients [11]. Rheumatoid factors, perinuclear anti-neutrophil cytoplasmic antibody, anti-smooth muscle antibody, anti-mitochondrial antibody, anti-nuclear antibody, and anti-microsome antibody have also been variably reported in AIP patients [12].
The hallmark findings of the pancreas on computed tomography imaging in AIP patients include sausage-shaped enlargement with homogenous attenuation, moderate enhancement, and a low-density rim surrounding the pancreas which represents the fibrotic and inflamed peripancreatic adipose tissue [13]. On endoscopic retrograde cholangiopancreatography, focal, segmental, or diffuse attenuation of the main pancreatic duct, the disappearance of right-angled branches, and narrowing of the intrapancreatic portion of the common bile duct may be identified [13]. Meanwhile, the role of transabdominal ultrasonography and magnetic resonance imaging in diagnosing AIP has not been well established.
DIAGNOSIS
In the last decade, many AIP criteria have been established, with distinct diagnostic criteria in different regions of the world. Most Asian criteria require pancreatic duct imaging via endoscopic retrograde pancreatography (ERP) or magnetic resonance pancreatography (MRP). However, the Mayo Clinic criteria does not require ERP/MRP evaluation, since the current practice in the United States does not include routine ERP/MRP for evaluation of obstructive jaundice [14, 15]. International consensus diagnostic criteria (ICDC) for AIP was established in 2011 by the International Association of Pancreatology to unify these diagnostic criteria while accommodating regional differences in practice and strategy [14, 16].
The diagnostic criteria uses a combination of 1 or more 5 cardinal features of AIP, including imaging, serology, other organ involvement, histopathology of the pancreas, and response to steroid therapy [16]. Each of these components may provide highly suggestive (level 1) or supportive (level 2) evidence and the different combinations of these features are considered diagnostic for AIP. The cardinal features of type 1 and type 2 AIP are summarized in Table 1.
Table 1. Cardinal features of type 1 and type 2 AIP.
|
Cardinal features |
Type 1 AIP |
Type 2 AIP |
|
Imaging |
Parenchymal imaging: Diffuse enlargement with delayed enhancement. Ductal imaging: Long or multiple strictures without marked upstream dilatation. |
Parenchymal imaging: Diffuse enlargement with delayed enhancement. Ductal imaging: Long or multiple strictures without marked upstream dilatation. |
|
Serology |
Elevated IgG (>2x upper limit of normal value). |
Normal level of IgG. |
|
Other organ involvement (OOI) |
Histologic or radiologic evidence of extrapancreatic organ involvement (Unrelated autoimmune diseases should not be included as OOI). |
None (Associated with inflammatory bowel disease). |
|
Histology |
Lymphoplasmacytic sclerosing pancreatitis. |
Idiopathic duct-centric pancreatitis. |
|
Response to steroid |
Rapid (<2 weeks) radiologically demonstrable resolution or marked improvement in pancreatic/ extrapancreatic manifestations. |
Rapid (<2 weeks) radiologically demonstrable resolution or marked improvement in pancreatic/ extrapancreatic manifestations. |
Endoscopic Ultrasound-Guided Fine Needle Aspiration
EUS-FNA has become the preferred method to evaluate pancreatic lesions. The main goal of EUS-FNA in patients with pancreatic masses is to detect or exclude malignancy. A definitive diagnosis of AIP via FNA is often challenging because of the limited tissue samples and nonspecific cytologic findings. Type 1 AIP patients can often be diagnosed without histology, while type 2 AIP requires an adequate histological specimen to make a definitive diagnosis [16]. Biopsies showing some but not all features of lymphoplasmacytic sclerosing pancreatitis or idiopathic duct-centric chronic pancreatitis can be used as supportive evidence for diagnosing AIP [16].
The most common EUS findings in AIP patients include diffuse swelling and hypoechoic pancreas, a solitary irregular mass, lymphadenopathy, vascular involvement, and fibrosis [17]. Some of these findings are similar to the EUS findings of pancreatic cancer. Diffuse hypoechoic areas, diffuse enlargement, bile duct wall thickening, and peripancreatic hypoechoic margins are reported to be more commonly seen in AIP compared to pancreatic cancer cases [18]. Recently, contrast-enhanced EUS and EUS elastographic techniques have been developed to improve the diagnostic accuracy of AIP [19].
According to ICDC for AIP, EUS-FNA is not recommended for the histologic diagnosis of AIP because of the difficulty in collecting an adequate amount of tissue samples [20]. However, tissue samples obtained using EUS-tru-cut biopsy and EUS-FNA using a large gauge needle have been considered useful for the diagnosis of AIP [19]. Farrell et al. reported that 73% of type 1 AIP patients who underwent EUS-FNA in their study showed cytomorphologic evidence of chronic inflammation with lymphoplasmacytic infiltrates (Figure 1a) and fibrosis (Figure 1b) [17]. Mild atypia of acinar and ductal epithelial cells (Figure 1c) can also be seen, and should be interpreted cautiously [12]. For this reason, a small percentage of FNA samples from AIP patients may be interpreted as atypical or suspicious for malignancy [17]. Diagnosis of AIP in a needle biopsy should be done cautiously as AIP may coexist with pancreatic cancer. Zhang et al. reported that AIP was also seen in 9.5% of pancreatic cancer patients [21].



|
Figure 1. Cytologic findings in type 1 autoimmune pancreatitis include lymphoplasmacytic infiltrates (a.) and fibrotic stroma (b.). Epithelial cells with mild atypia can also be identified (c.). (Diff Quik stain, 20x) |
The histologic characteristics of type 1 AIP in the hematoxylin and eosin-stained biopsies or resection specimens include a dense lymphoplasmacytic infiltrate, which are predominantly CD4 T lymphocytes, fibrotic stroma, intraductal neutrophilic infiltration, periphlebitis and venulitis (Figure 2), epithelioid granulomas, and inflammatory pseudotumor [12].
|
Figure 2. Permanent section of the fine needle aspirate showing venulitis, characterized by lymphoplasmacytic inflammation surrounding the vein. (Hematoxylin and eosin, 20x). |
IgG4 immunoperoxidase may be helpful to support the diagnosis of type 1 AIP in the appropriate clinical contexts. Dhall et al. reported that diffuse and dense staining for IgG4 (Figure 3) is a specific finding for lymphoplasmacytic sclerosing type of AIP [22]. However, this immunohistochemical study should be interpreted carefully since IgG4-positive plasma cells can also be seen in pancreatic cancer cases [23].

|
Figure 3. Immunohistochemical study highlighting IgG4-positive plasma cells. (IgG4 stain, 20x). |
Idiopathic duct-centric pancreatitis is the characteristic histologic feature of type 2 AIP, which include granulocytic infiltration of duct wall with or without granulocytic acinar inflammation and absent or scant (0-10 cells/ HPF) IgG4-positive cells [16].
Molecular Techniques
V-Ki-Ras2 Kristen rat sarcoma viral oncogene (KRAS) mutations are frequently identified in pancreatic cancer cases. Cai et al. reported that KRAS mutation has a high predictive value for malignancy in patients with indeterminate pancreatic cytology specimen [24]. However, KRAS mutation analysis has a low specificity as it may also be seen in benign conditions, including AIP [25].
MicroRNA (miR) is a small non-coding RNA which plays important gene regulatory roles in different biological processes. Recent studies have shown that miR expression in pancreatic lesions is useful to differentiate malignant processes from benign entities [26, 27]. Szafranska et al. reported the potential utility of miR analysis of pancreatic FNA biopsy samples in diagnosing pancreatic lesions [28]. In their study, the quality and amounts of cells sampled via EUS-FNA were adequate for successful polymerase chain reaction analysis. MiR-196a over expression is consistently seen in pancreatic cancer cases, but not in benign lesions [28].
TREATMENT AND OUTCOME
Both type 1 and type 2 AIP patients show an excellent response rate towards steroid treatment. The current recommendation is daily dose of 30-40 mg for 4-6 weeks and then gradually tapered within 2-3 months [29]. Relapse rates have been reported to be similar in type 1 and type 2 AIP. Maire et al. reported relapse occurred in 27% of 44 AIP patients, and it was more frequent in patients with high serum IgG4 levels at the time of diagnosis [30]. Diabetes mellitus is more commonly seen in type 1 AIP patients, which can be explained by the higher rate of pancreatic resection and the older age of these patients. Azathioprine, an immunomodulatory drug, has been reported to be a useful steroid-sparing agent for patients who relapse during steroid withdrawal [30]. In addition, rituximab treatment is highly effective for induction and maintenance of remission in AIP patients, including those who are resistant to immunomodulatory treatment [31]. Pancreatic cancer has also been reported in AIP patients. It is very likely that the process of chronic inflammation and fibrosis may increase the risk of malignancy in these patients [14, 31].
CONCLUSION
Diagnosis of AIP requires a multidisciplinary approach. Histological evaluation is one of the cardinal features in diagnosing AIP according to ICDC. EUS-FNA is a useful tool in the diagnosis and management of AIP patients. The main goal of EUS-FNA in these patients is to exclude a malignant process, since its utility to establish a definite diagnosis of AIP is limited. Histologic findings which are supportive of the diagnosis include lymphoplasmacytic infiltrates, fibrotic stroma, mildly atypical epithelial cells, periphlebitis, obliterative periphlebitis for type 1 AIP and granulocytic pancreatic ductal epithelial damage and ductal obliteration for type 2 AIP. IgG4 immunohistochemistry and molecular testing, such as KRAS mutation and miR analysis, may be helpful to establish the diagnosis of AIP in EUS-FNA.
Received March 8th, 2015-Accepted April 02nd, 2015
Keywords Epidemiology
Conflicting Interest The authors had no conflicts of interest
Correspondence Juan Putra
Department of Pathology
Dartmouth-Hitchcock Medical Center
One Medical Center Drive
Lebanon, NH 03756
USA
Phone: +1 603 443 7161
E-mail: juan.putra@hitchcock.org
References
1. Yoshida K, Toki F, Takeuchi T, Watanabe S, Shiratori K, Hayashi N. Chronic pancreatitis caused by an autoimmune abnormality: proposal of the concept of autoimmune pancreatitis. Dig Dis Sci 1995; 40:1561-68. [PMID: 7628283]
2. Hart PA, Kamisawa T, Brugge W, et al. Long-term outcomes of autoimmune pancreatitis: a multicentre, international analysis. Gut 2013; 62:1771-6. [PMID: 2323048]
3. Sarles H, Sarles JC, Muratoren R, Guien C. Chronic inflammatory sclerosing of the pancreas-an autonomous pancreatic disease? Am J Dig Dis 1961; 6:688-98. [PMID: 13746542]
4. Gardner TB, Levy MJ, Takahashi N, Smyrk TC, Chari ST. Misdiagnosis of autoimmune pancreatitis: a caution to clinicians. Am J Gastroenterol 2009; 104:1620-3. [PMID: 19574965]
5. Hardacre JM, Iacobuzio-Donahue CA, Sohn TA, et al. Results of pancreaticoduodenectomy for lymphoplasmacytic sclerosing pancreatitis. Ann Surg 2003; 237:853-9. [PMID: 12796582]
6. Kim KP, Kim MH, Song MH, Lee SS, Seo DW, Lee SK. Autoimmune chronic pancreatitis. Am J Gastroenterol 2004; 99:1605-16. [PMID: 15307882]
7. Pearson RK, Longnecker DS, Chari ST, et al. Controversies in clinical pancreatology: autoimmune pancreatitis: does it exist? Pancreas 2003; 27:1-13. [PMID: 12826899]
8. Park DH, Kim MH, Chari ST. Recent advances in autoimmune pancreatitis. Gut 2009; 58:1680-9. [PMID: 19240063]
9. Sah RP, Chari ST, Pannala R, et al. Differences in clinical profile and relapse rate of type 1 versus type 2 autoimmune pancreatitis. Gastroenterology 2010; 139:140-8. [PMID: 20353791]
10. Chari ST, Kloeppel, Zhang L, et al. Histopathologic and clinical subtypes of autoimmune pancreatitis: the Honolulu Consensus Document. Pancreatology 2010; 10:664-72. [PMID: 21242705]
11. Agrawal S, Daruwala C, Khurana J. Distinguishing autoimmune pancreatitis from pancreaticobiliary cancers. Ann Surg 2012; 255:248-58. [PMID: 21997803]
12. Deshpande V, Mino-Kenudson M, Brugge W, Lauwers GY. Autoimmune pancreatitis: more than just a pancreatic disease? A contemporary review of its pathology. Arch Pathol Lab Med 2005; 129:1148-54. [PMID: 16119989]
13. Finkelberg DL, Sahani D, Deshpande V, Brugge W. Autoimmune pancreatitis. N Engl J Med 2006; 355:2670-6. [PMID: 17182992]
14. Sah RP, Chari ST. Autoimmune pancreatitis: an update on classification, diagnosis, natural history and management. Curr Gastroenterol Rep 2012; 14:95-105. [PMID: 22350841]
15. Chari ST, Takahashi N, Levy MJ, et al. A diagnostic strategy to distinguish autoimmune pancreatitis from pancreatic cancer. Clin Gastroenterol Hepatol 2009; 7:1089-96. [PMID: 19410017]
16. Shimosegawa T, Chari ST, Frulloni L, et al. International consensus diagnostic criteria (ICDC) for autoimmune pancreatitis: guidelines of the International Association of Pancreatology. Pancreas 2011; 40:352-8. [PMID: 21412117]
17. Farrell JJ, Garber J, Sahani D, Brugge WR. EUS findings in patients with autoimmune pancreatitis. Gastrointes Endosc 2004; 60:927-36. [PMID: 15605008]
18. Hoki N, Mixuno N, Sawaki A, et al. Diagnosis of autoimmune pancreatitis using endoscopic ultrasonography. J Gastroenterol 2009; 44:154-9. [PMID: 19214678]
19. Kamisawa T, Ohara H, Kim MH, Kanno A, Okazaki K, Fujita N. Role of endoscopy in the diagnosis of autoimmune pancreatitis and immunoglobulin G4-related sclerosing cholangitis. Dig Endosc 2014; 26:627-35. [PMID: 24712522]
20. Imai K, Matsubayashi H, Fukutomi A, et al. Endoscopic ultrasonography-guided fine needle aspiration biopsy using 22-gauge needle in diagnosis of autoimmune pancreatitis. Dig Liver Dis 2011; 43:869-74. [PMID: 21733766]
21. Zhang X, Liu X, Joseph L, et al. Pancreatic ductal adenocarcinoma with autoimmune pancreatitis-like histologic and immunohistochemical features. Hum Pathol 2014; 45:621-7. [PMID: 24457081]
22. Dhall D, Suriawinata AA, Tang LH, Shia J, Klimstra DS. Use of immunohistochemistry for IgG4 in the distinction of autoimmune pancreatitis from peritumoral pancreatitis. Hum Pathol 2010; 41:643-52. [PMID:20149413]
23. Resheq YJ, Quaas A, von Renteln D, Schramm C, Lohse AW, Luth S. Infiltration of peritumoral but tumour-free parenchyma with IgG4-positive plasma cells in hilar cholangiocarcinoma and pancreatic adenocarcinoma. Dig Liver Dis 2013; 45:859-65. [PMID: 23602806]
24. Cai G, Mahooti S, Lipata FM, Chhieng D, Hui P. Diagnostic value of k-ras mutation analysis for pancreaticobiliary cytology specimens with indeterminate diagnosis. Cancer Cytopathol 2012; 120:313-8. [PMID: 22367918]
25. Kamisawa T, Tsuruta K, Okamoto A, et al. Frequent and significant K-ras mutation in the pancreas, the bile duct, and the gallbladder in autoimmune pancreatitis. Pancreas 2009; 38:890-5. [PMID: 19752775]
26. Bloomston M, Frankel WL, Petrocca F, et al. MicroRNA expression patterns to differentiate pancreatic adenocarcinoma from normal pancreas and chronic pancreatitis. JAMA 2007; 297:1901-8. [PMID: 17473300]
27. Xue Y, Abou Tayoun AN, Abo KM, Pipas JM, Gordon SR, Gardner TB, et al. MicroRNAs as diagnostic markers for pancreatic ductal adenocarcinoma and its precursor, pancreatic intraepithelial neoplasm. Cancer Genet 2013; 206:217-21. [PMID: 23933230]
28. Szafranska AE, Doleshal M, Edmunds HS, et al. Analysis of microRNAs in pancreatic fine-needle aspirates can classify benign and malignant tissues. Clin Chem 2008; 54:1716-24. [PMID: 18719196]
29. Okazaki K, Kawa S, Kamisawa T, et al. Japanese clinical guidelines for autoimmune pancreatitis. Pancreas 2009; 38:849-66. [PMID: 19745774]
30. Maire F, Baleur YL, Rebours V, et al. Outcome of patients with type 1 or 2 autoimmune pancreatitis. Am J Gastroenterol 2011; 106:151-6. [PMID: 20736934]
31. Hart PA, Topazian MD, Witzig TE, et al. Treatment of relapsing autoimmune pancreatitis with immunomodulators and rituximab: the Mayo Clinic experience. Gut 2013; 62:1607-15. [PMID: 22936672]